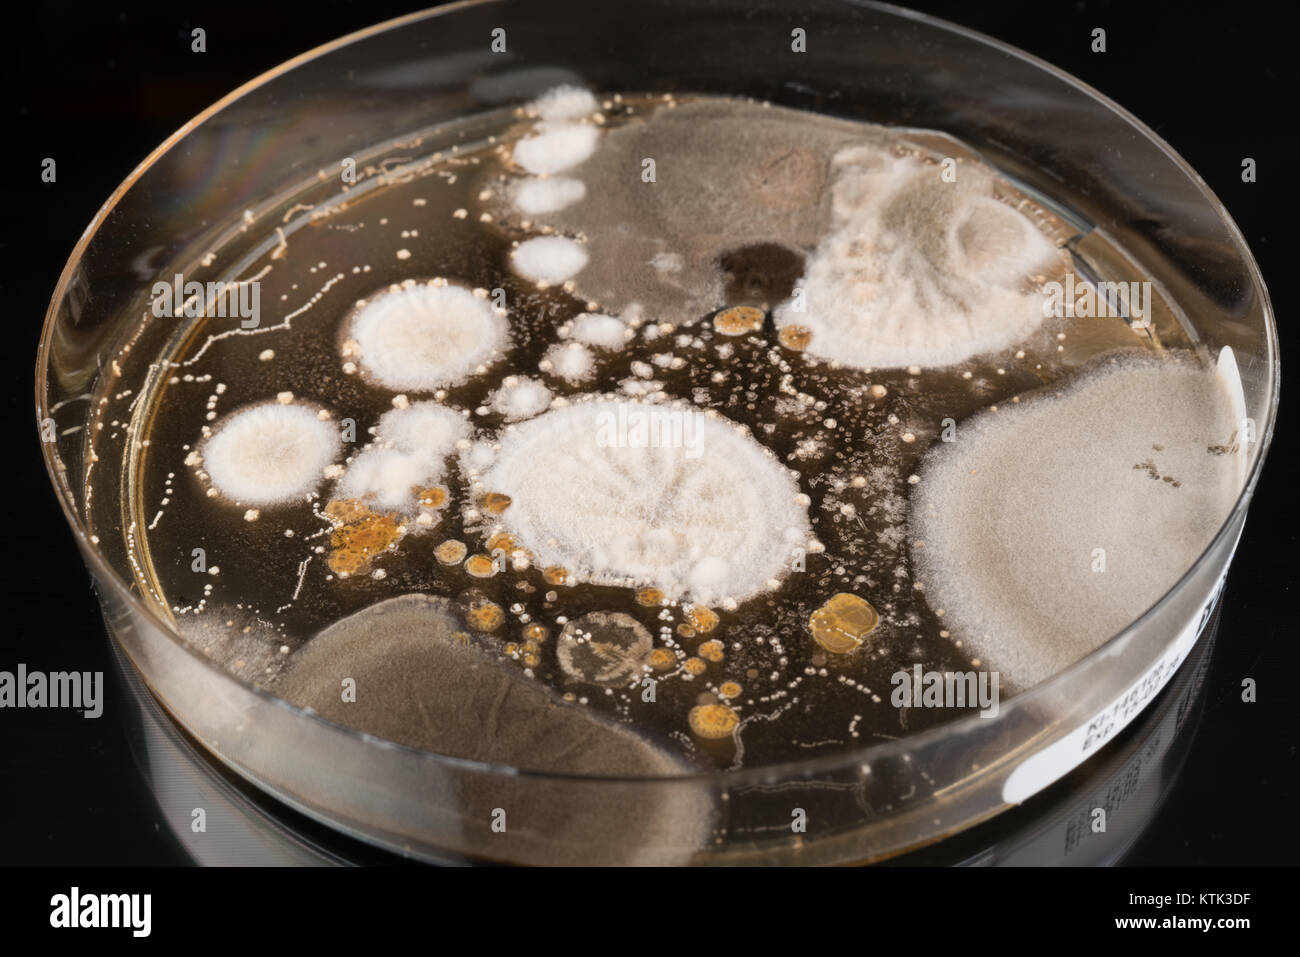
Scientist Growing Bacteria In Petri Dishes On Agar Gel As A 54 OFF

If you are having a hard time accessing the How To Count Bacteria In A Petri Dish page, Our website will help you. Find the right page for you to go to How To Count Bacteria In A Petri Dish down below. Our website provides the right place for How To Count Bacteria In A Petri Dish.

EXCEL COUNT
https://jingyan.baidu.com › article
EXCEL 2007 5 COUNT COUNTA COUNTBLANK COUNTIF COUNTIFS 5

Count On Me
https://jingyan.baidu.com › article
Count On Me Peter Gene Hernandez 1985 10 8 Bruno Mars
Thank you for visiting this page to find the login page of How To Count Bacteria In A Petri Dish here. Hope you find what you are looking for!